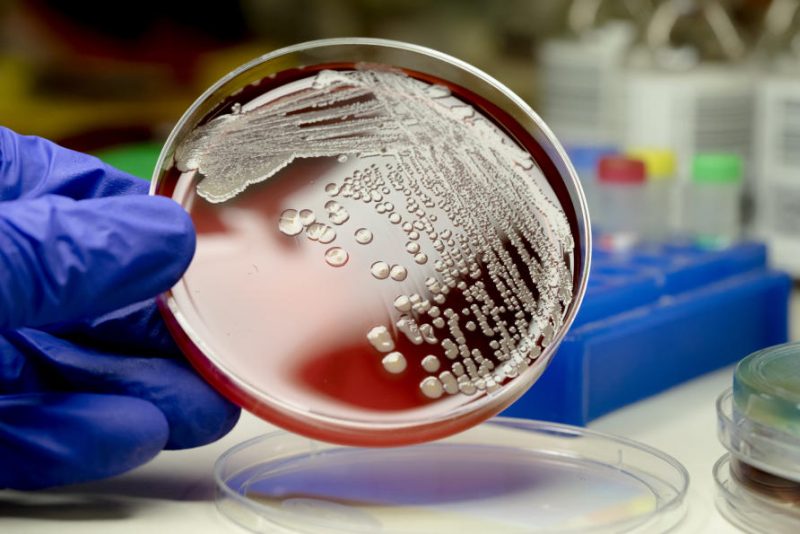

Una “superbacteria” resistente a todos los antibióticos coloniza hospitales en el mundo entero
Un “formidable” microorganismo patógeno, potencialmente fatal y resistente a todos los antibióticos conocidos, se ha esparcido por hospitales de todo el mundo, sugiere una investigación realizada por un equipo de expertos de la Universidad de Melbourne (Australia), informa el sitio oficial de esa institución.
El estudio, publicado el pasado 3 de septiembre en la revista Nature Microbiology, se basó en el análisis de muestras recogidas en 78 instituciones médicas de 10 países diferentes. La investigación permitió detectar en los nosocomios la presencia del microbio Staphylococcus epidermidis (también conocido como S. epidermis), el cual surgió hace unas décadas y ha llegado a esparcirse a nivel global.
La bacteria “suele colonizar la piel” y “no necesariamente lleva a una infección”, pero “en una cantidad reducida de personas puede provocar infecciones serias e invasivas”, las cuales “requieren de tratamientos complejos”, explicó Ben Howden, el autor principal del trabajo, según recoge ABC News Australia.
El S. epidermis es un pariente de la ‘superbacteria’ Estafilococo aureus resistente a la meticilina (SARM), la cual ha desarrollado una resistencia a la mayoría de los antibióticos que se utilizan para combatir este tipo de infecciones, aunque normalmente no afecta a la mayoría de las personas.
Sin embargo, puede significar un peligro potencialmente severo e incluso mortal para pacientes con sistemas inmunológicos debilitados, así como para aquellos que se recuperan de una cirugía o que tienen implantes médicos tales como catéteres y articulaciones artificiales.
El estudio indica que las prácticas hospitalarias, incluyendo la prescripción inapropiada de antibióticos en las unidades de cuidados intensivos, “puede haber impulsado la evolución de este organismo”, cuyo potencial contaminante fue subestimado en su momento, “hacia infecciones potencialmente incurables”. (RT)

